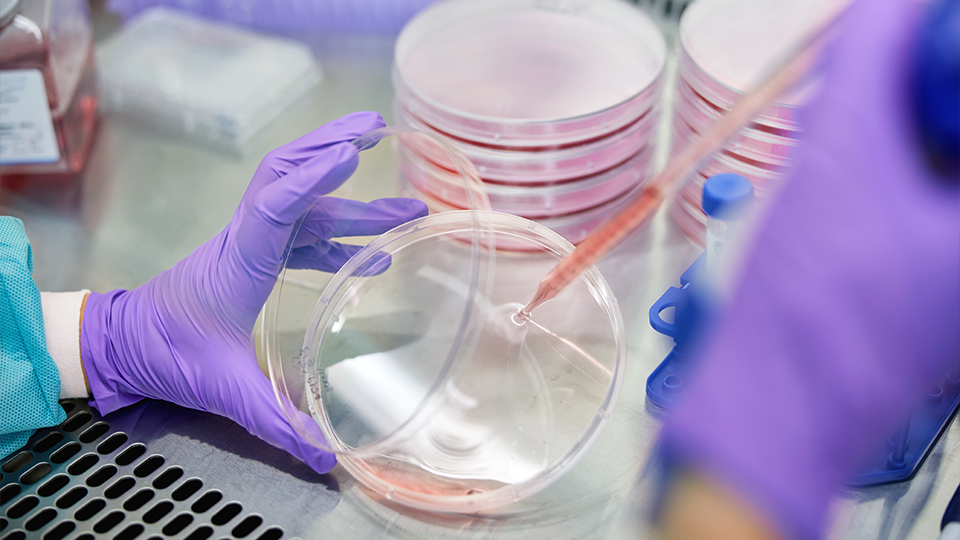
A scientist uses a pipette in the lab.

Join Us
At Dispatch, we’re striving with passion and urgency to fundamentally transform cancer treatment. We’re combining two rapidly advancing fields — immunotherapy and gene therapy — and building a team with diverse expertise to achieve our ambitious mission.
Our values
We’re humbled by the opportunity to work together on some of the most pressing medical challenges of our time. Our vision to provide cancer patients and their families with a real cure inspires our innovation each and every day.
Determined to deliver

Own every outcome

Collaboration at the core

Feedback is fundamental
Current openings
There are no openings currently at Dispatch Biotechnologies, please comeback later.
Working at Dispatch
We’re committed to making Dispatch a home for today’s bright stars as well as tomorrow’s leaders. We provide our team with a supportive, collaborative environment that allows individuals to grow and the entire group to succeed.
Benefits
We respect that our lives extend beyond the work we do at Dispatch, and we provide our team with a robust, best-in-class benefits package.
Locations
Dispatch has state-of-the-art research and development facilities in Philadelphia and San Francisco. This enables us to attract talent from two of the leading scientific hubs in the country and to foster collaborations with world-class scientists.
A culture driven by science
Our path to innovation is grounded in a shared commitment to scientific rigor and collaboration. We foster a workplace that supports the open exchange of ideas and high standards of integrity, enabling our teams to do their best work and advance meaningful progress for patients. We are an equal opportunity employer and make employment decisions in accordance with applicable laws.

